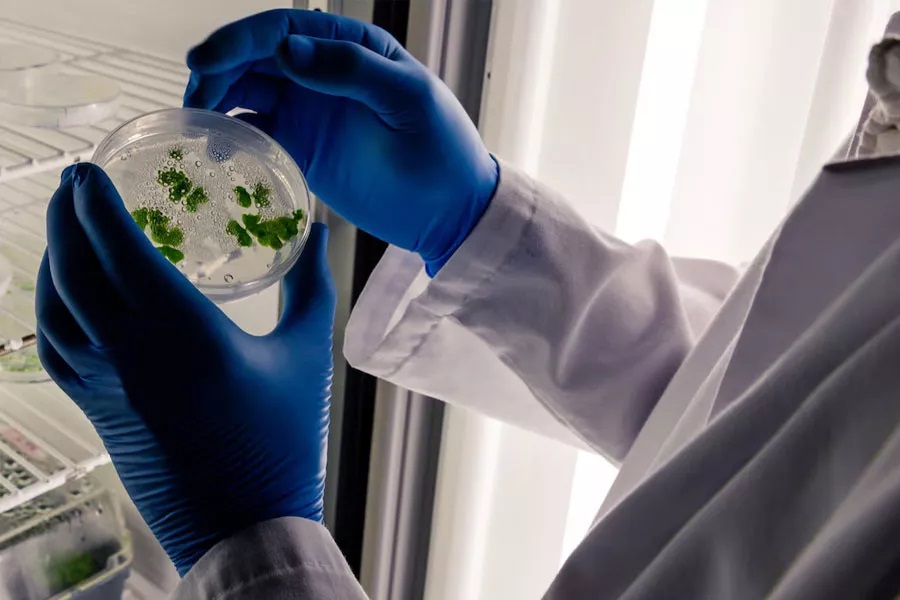

- Home
- Companies
- Puroxi Pure Water Global Inc.
- Articles
- Cleaner Clarifying Tanks through ...
Cleaner Clarifying Tanks through Ultrasonic Innovation
Clean water treatment needs more innovative tools. Today, many facilities look for systems that deliver fast results without chemicals. Therefore, ultrasonic technology has become a powerful option. It improves tank clarity, reduces manual work, and boosts operational stability. Most importantly, it transforms how treatment plants handle algae. The Ultrasonic algae clarifier tank approach is now leading this shift.

Clarifying tanks face one common problem. Algae grows fast and affects water clarity. It also weakens treatment efficiency. However, ultrasonic solutions change this challenge. They target algae at the source. They disrupt algae growth cycles in minutes. As a result, operators see cleaner tanks and more consistent performance.
Traditional methods struggle with heavy blooms. Yet the Ultrasonic algae clarifier tank setup uses sound waves to break algae cells. The waves create microscopic pressure shifts. These shifts shock algae membranes. Therefore, the algae cannot reproduce. It becomes inactive quickly. The process is fast and reliable.
Moreover, the method does not use chemicals. Many industries prefer this. It protects downstream processes. It also keeps the environment safe. The algae control clarifiers’ ultrasonic approach fits modern sustainability goals. It uses only power and controlled frequencies. Everything stays simple.
Operators hate downtime. Algal buildup often requires additional cleaning cycles. Yet the Ultrasonic algae clarifier tank technology limits these issues. It prevents new algae layers from forming. Therefore, tanks run longer between maintenance checks.
Flow improves. Settling improves. Even sludge removal becomes smoother. Additionally, the ultrasonic waves travel evenly across the tank. No corners go untreated. This uniform coverage makes the algae control clarifiers’ ultrasonic method highly dependable.
Midway through your operations planning, you may also consider expert guidance. Puroxi supports facilities that want clean, stable, and efficient clarifier systems with advanced ultrasonic tools.
Many plants rely on coagulation tanks. These tanks prepare water for settling and filtration. But algae disrupt the process. They interfere with coagulant binding. They also trap air and slow particle settling. Therefore, the coagulation tank algae treatment process becomes harder.
Ultrasonic tools correct this problem. They weaken algae clusters. As a result, coagulants attach faster. Floc grows evenly. The tank stays stable. Additionally, staff gain better control over each stage. The coagulation tank algae treatment method becomes more consistent. Operators can adjust dosages with confidence.
Furthermore, ultrasonic action reduces odor. It improves surface cleanliness. It prevents scum layers from forming. These benefits make the coagulation tank algae treatment approach essential for quality control.
Clarifiers shape the entire water-treatment cycle. When they stay clean, every step improves. Ultrasonic technology supports this. It enhances biological treatment. It improves chemical processes. It even protects filtration equipment. The Ultrasonic algae clarifier tank method strengthens system reliability.
Additionally, teams enjoy predictable outcomes. Algae no longer surprises them. They work with clear water daily. They avoid emergency fixes. The plant budget becomes stable.
The algae control clarifiers’ ultrasonic method also allows real-time management. Systems run automatically. Frequencies stay consistent. Teams only monitor performance. They save time and labor.

Sustainability matters. Many industries aim to limit chemical use. Ultrasonic tools help them reach this target. Sound waves alone handle algae. Therefore, operators reduce chemical interactions. They protect equipment as well. This creates a safer workplace.
The Ultrasonic algae clarifier tank solution keeps water structures healthy. It also supports eco-friendly goals. Many regions now prefer this path. As a result, more facilities adopt ultrasonic systems. The market grows each year.
Moreover, the algae control clarifier’s ultrasonic method works well in large and small tanks. It scales easily. It installs quickly. It starts working instantly.
Every plant watches expenses. Ultrasonic systems deliver savings fast. They cut chemical purchases. They reduce cleaning hours. They extend equipment life. They also minimize sludge volume. Therefore, total operating costs shrink.
Additionally, the Ultrasonic algae clarifier tank approach prevents the need for emergency repairs. Plants avoid sudden shutdowns. They enjoy stable operations. Over time, savings increase.
The coagulation tank algae treatment benefits also reduce chemical waste. This improves compliance. It also boosts sustainability scores.
Technology grows fast. Water treatment systems must evolve, too. Ultrasonic innovation fits this future. It is simple, clean, and effective. It handles algae better than traditional systems. It keeps clarifiers stable. It keeps coagulation tanks strong. The algae control clarifiers’ ultrasonic strategy also adapts to automation. Many plants now integrate sensors and intelligent controls. Ultrasonic tools fit perfectly into this trend.
Ultrasonic innovation is reshaping how treatment plants manage algae. With stronger clarity, lower chemical use, and improved stability, the Ultrasonic algae clarifier tank system sets a new standard. It ensures cleaner tanks. It supports long-term reliability. It benefits the environment and the budget.
Puroxi proudly helps industries adopt this modern approach. With expert support and advanced tools, your plant can reach new performance levels.
